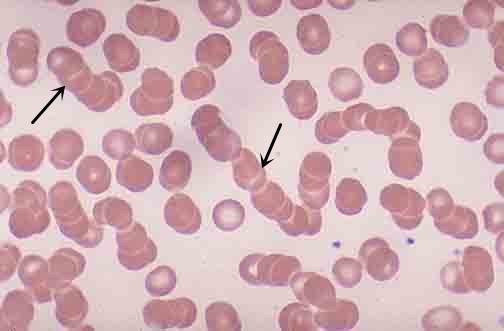
红细胞叠连

缗钱状红细胞

(图) 缗钱状红细胞
图片尺寸1139x908
缗钱状红细胞 2017102 请报告箭头所指细胞的名称
图片尺寸640x476
红细胞缗钱状排列居然是因为他
图片尺寸1040x770
缗钱状红细胞 (其他生物相关)
图片尺寸475x464
红细胞缗钱状排列居然是因为他
图片尺寸1040x770
红细胞叠连
图片尺寸504x331
红细胞缗钱状排列居然是因为他
图片尺寸1040x770
红细胞呈钱串状
图片尺寸220x168
红细胞缗钱状排列 冷凝集,红系统多个参数出现问题怎么破?
图片尺寸690x460
红细胞缗钱状排列!幼稚粒!胸背疼痛!指向啥病?下一步要做哪些检查?
图片尺寸1206x1080
【徐萍】跟师一读(12)"红细胞缗钱状"
图片尺寸300x300
【徐萍】跟师一读(12)"红细胞缗钱状"
图片尺寸1194x680
红细胞缗钱状排列居然是因为他
图片尺寸1040x770
红细胞呈钱串状图集
图片尺寸300x220
红细胞缗钱状排列居然是因为他
图片尺寸1040x770
但随着时间的推逝,室温放置的1号血袋的红细胞开始凝集呈缗钱状(图5)!
图片尺寸396x407
ibd血清白蛋白的早期变化可预测溃疡性结肠炎患者开始
图片尺寸900x674
图片
图片尺寸263x283
需要提醒的是,血涂片中红细胞呈缗钱状也仅仅提示浆细胞有问题,但并
图片尺寸510x347
看图识细胞第62期
图片尺寸1040x770